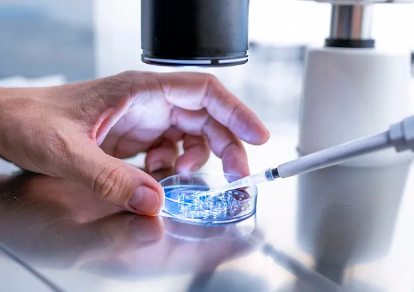
南京试管代怀百科,医院有规定什么样的病人才能做试管婴儿_南京公立医院供卵

南京试管代怀百科,医院有规定什么样的病人才能做试管婴儿_南京公立医院供卵
发布时间:2025-01-23
回复: '试管婴儿一般适合女性,有严重的输卵管疾病的人群,比如出现了盆腔炎,没有及时的治疗,或者比较严重时导致了输卵管堵塞或者是积水的情况下,是可以做试管婴儿的。另外也适合子宫内膜异位症或者是免疫性不孕症,做了宫外孕手术之后导致了输卵管堵塞的人群。对于男性出现的少精,弱精,畸精症的人群来说,也可以使用这些方法。同时对于卵泡不破裂综合症的人群或者是遗传性疾病的人群,都可以使用此方法。
法律规定教师做试管婴儿的假吗
回复: 法律规定教师做试管婴儿?那是不可能的事情,除非是国家疯了,才会出现这样的事情。做试管婴儿完全是自愿的。没有这样的事情。去泰国做试管婴儿规定带哪些办理手续
泰国试管婴儿技术水平优秀,成功率高,协助了许多不育不孕的家中,也是吸引了许多的中国人去泰国做试管婴儿。由于各种原因,许多的姐妹们提前准备做泰国试管婴儿,可是也有脑中也有许多的疑虑,向也了解了许多的难题:比如去泰国做试管婴儿必须准备充分什么办理手续呢?今日,就给我们讲下,去泰国做试管婴儿规定带哪些办理手续。
一、护照签证解决,这必须到户口所在地解决护照签证,只需各自带身份证件前去。
二、泰国签证办理解决
(1)提前准备泰国旅游签证办理解决所需原材料:护照签证正本(有效期限6个月之上);二寸彩色相片2张;填申请表格;泰国旅游签证办理加急的情况下费用600元(二个工作中日);泰国旅游签证办理加急的情况下费用800元(一个工作中日)
(2)怎么处理一般泰国旅游签证办理?可以自行解决或信赖技术专业的代理公司解决,自然您可以立即信赖我们帮您解决赴泰签证办理,可以节省您大量的时时刻刻。
自然泰国是落地签国家,假如在时时刻刻较为激动的情形下,赶不及在中国解决签证办理可以考虑到立即在泰国解决落地签。
三、赴泰进周,助孕归国
女性在月经第二天赴泰见预定好的医师,开展促排,卵子成熟试管婴儿取卵,随后跟据病人的状况开展移殖,随后测怀孕归国。这在其中取过精子和卵子以后如果有事儿是可以把试管胚胎冷藏起來,过一段时时刻刻过去开展移殖,时时刻刻是可以泛娱乐化来完成实际操作的。
之上是为您讲解的去泰国做试管婴儿规定带哪些办理手续,是全世界辅助生殖行业较大跨境电商医疗管理公司,为您给予一站式试管婴儿项目实施方案,有想深入了解的小伙伴可以来资询哦!
相关推荐
- 代怀男孩-试管婴儿移植后着床成功的症状
- 南京专业代孕双胞胎,南京试管双胎龙凤胎多还是同性多_正规试管助孕机构-试管
- 南京试管助孕哪里找 在南京鼓楼医院试管取卵疼吗? ‘女孩的彩超单什么样’
- 南京试管代生机构,南京三代试管婴儿的费用和成功率是多少?
- 南京代怀网多少费用 2024南京冷冻卵子医院排名 ‘31周时股骨长怎么测男女?’
- 南京好孕代孕网,第三代试管婴儿对无精子症的男性还能生育下一代吗?_上海供卵
- 南京代孕机构都有哪些,试管婴儿移植后胚胎不发育什么原因-南京供卵试管婴儿
- 南京供卵试管生双胞胎电话 南京鼓楼三代试管费用 ‘做彩超时怎么看男女’
- 南京代孕二胎费用 2024南京私立供卵机构排名火热发布 ‘胎囊1.2×1.3×9看男女’
- 南京试管代怀多久时间 2024南京三代试管婴儿费用多少? ‘32周双顶径看男女’
热门文章
- 南京无性供卵代怀,2024年南京鼓楼医院试管婴儿费用要多少钱?附南京试管医院
- 南京供卵代生产医院,南京三代试管婴儿医院排名?附医院名单?
- 南京代生供卵咨询,南京试管婴儿医院排名如何?
- 南京哪家供卵生宝宝,南京军总供卵试管
- 南京代怀中心收费 南京鼓楼医院试管婴儿医生推荐: ‘胎囊数据看男女准吗’
- 南京好孕代孕网,第三代试管婴儿对无精子症的男性还能生育下一代吗?_上海供卵
- 南京代生宝宝价格,南京做试管多少钱啊?试管婴儿价位是多少?
- 南京代孕二胎费用 2024南京私立供卵机构排名火热发布 ‘胎囊1.2×1.3×9看男女’
- 南京个人代孕价格,试管内膜多少可以移植_试管移植后可以喝黑鱼汤吗_子宫膜过
- 南京代怀孕公司上班好吗 南京中大医院生殖医学中心 ‘孕16周三维看男女’

